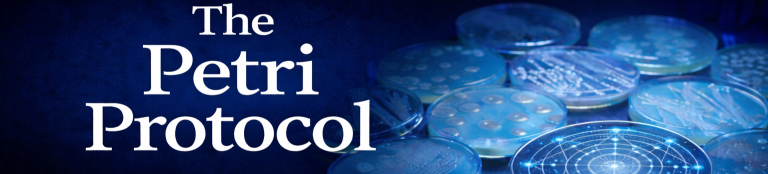

What if the universe isn’t what we think it is?
What if the oldest light in existence, the cosmic microwave background, wasn’t just noise……but evidence?
The Petri Protocol is a 30-chapter serialized novel released one chapter at a time.
It begins with a scientist reviewing routine deep-space data.
It ends with a question humanity may not be ready to answer.
New chapters are released daily.
If you’re just starting, you’re in the right place.
Chapters post daily, starting April 27, at 8:00 p.m.